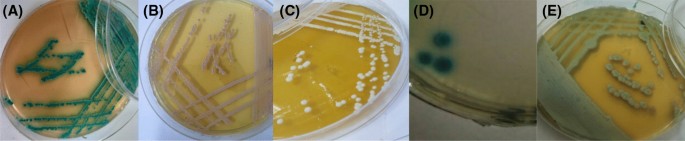

- Research
- Open access
- Published:
Isolation and identification of Candida spp. from immunocompromised patients
Bulletin of the National Research Centre volume 45, Article number: 163 (2021)
Abstract
Background
Candida species is considered one of the normal inhabitant commensal microbiota of the human body. However, it can also act as an opportunistic pathogen especially in hospitals (nosocomial infection) and among immunocompromised patients. The accurate, precise, rapid and reliable identification of Candida to the species level is of great importance for control and management of candidiasis.
Results
One hundred and eighteen different samples were collected (59 urine samples, 39 oral swabs, 5 vaginal swabs and 15 skin swabs) from immunocompromised patients (diabetics—pregnant women—patients underwent organ transplantation—cancer patients—burned and wounded patients) for probable existence of Candida species. Eighty-six out of 118 (72.8%) samples were typed macroscopically and microscopically and found to be Candida species. Upon streaking 86 Candida isolates on CHROMagar plates separately, 48 isolates gave green colonies, 25 isolates gave rose colonies, 10 isolates gave white colonies, 2 isolates gave pale coloured colonies and 1 isolate gave blue colonies. Forty-eight out of 86 isolates showed positive Germ tube test. API 20C assay was performed on some isolates with different coloured colonies, the results were similar to those of CHROMagar. Upon performing PCR assay on 14 isolates using ITS1 and ITS4 primers, 8 out of 14 PCR product bands appeared between 510 and 535 bp and this was difficult to differentiate among them (C. albicans, C. tropicalis, C. krusei and C. parapsilosis). Five out of 14 PCR products were found at 871 bp (C. glabrata) and the last one is negative control with no band appeared. Further molecular studies should be recommended to fully differentiate among Candida species especially those with very close bands. Antifungal activity (expressed by inhibitory zone) of zinc oxide nanoparticles in comparison with some commercially available antifungals (nystatin and Voriconazole) was carried upon the obtained Candida isolates. Zinc oxide nanoparticles with 100 μg/disc showed 9, 26, 40, 42 mm inhibitory zones for C. tropicalis, C. glabrata, C. albicans and C. parapsilosis, respectively. However, zinc oxide only showed no antifungal activity against C. krusei.
Conclusions
A sheet of identification profile for Candida should include morphotyping, biotyping and genotyping to reach a rapid, reliable and accurate diagnosis. Candida species causes a myriad of infections causing non-invasive, mucocutaneous infections and severe systemic and deep-seated disease. Repress of Candida growth by ZnONPs provides an insight towards their therapeutic application for the prevention of Candida-associated infections. Further studies on the antifungal effect of nanoparticles combined with commercially available antifungal medicines maybe recommended.
Background
Candida is a polymorphic fungus, it is oval, Gram positive, budding yeast cell that produces pseudohyphae both in culture and in tissues and exudates (Ogaba et al. 2013). Opportunistic fungal infections are a major threat to immunocompromised patients (Hawkins and Armstrong 1984). Many factors can compromise the immune system, including low birth weight, cancer, diabetes, AIDS, burns and organ transplantation (Page and Kurtzman 2005). Identification of Candida species causing infections is important for treatment, as not all species respond to the same antimicrobial agent. The ability to detect many different species has become critical as the emergence of non-C. albicans Candida species continues to be increasingly documented (Page and Kurtzman 2005). C. albicans is the most frequently reported species causing human infection, but other species are also reported: including C. glabrata, C. parapsilosis, C. tropicalis and C. krusei, and others (Montes et al. 2019). Phenotypic methods are considered the routine identification of yeast species isolated from clinical samples in many hospitals, through two parts; macroscopic observation including shape, size, colour of colony on agar plate and microscopic observation of fungal structures in the clinical samples and culture and they are still considered the gold standard for identification (Montes et al. 2019). Generally the clinical culture is followed by biochemical based on chromogenic media for identifying the infecting species (Montes et al. 2019). Although these traditional methods are useful, they have some disadvantages, such as the prolonged time they take to generate results until the identification of the microorganism is complete. Moreover, they have limited sensitivity, therefore using nucleic acid-based assays such as PCR allow rapid identification of Candida species (Zhang et al. 2016). Most antifungal medicines used for candidiasis have shown some serious side effects and development of resistance in Candida strains which becomes a serious health concern (Ahmad et al. 2020). In recent research, some alternate antifungal therapy is being tried to make effective treatment options for the treatment of Candidiasis like many metal nanoparticles (NPs) which have been considered in the treatment of Candidiasis and have received significant results concern (Ahmad et al. 2020).
Methods
Sampling and isolation of fungal elements
One hundred eighteen samples were collected from private laboratory and private hospitals in Egypt from five sections of immunocompromised patients including 50 diabetic patients, 29 pregnant women, 5 patients underwent organ transplantation (liver And kidney), 19 cancer patients and 15 burned and wounded patients. The collected samples included 59 urine samples, 39 oral swabs, 5 vaginal swabs and 15 skin swabs. All the collected samples were subjected to fungal enrichment by inoculation into Sabouraud dextrose broth (SDB) tubes, then the tubes were incubated at 30 °C for 24 h and then examined visually for turbidity.
Phenotypic identification of the isolates
Turbid SDB tubes suspected to contain fungal elements were identified by morphotyping, macroscopic and microscopic examination according to Montes et al. (2019).
Macroscopic identification
A loopful taken from every turbid SDB tube was streaked on Sabouraud dextrose agar (SDA, Lot. no 1594522/Oxoid) with chloramphenicol (16 mg/ml, Neo Quimica) (Marinho et al. 2010). Then the plates were incubated at 30 °C for 48 h. Each grown colony was checked for size, colour and shape.
One single colony grown from each SDA plate was picked up and streaked on CHROMagar (CONDA, Spain) plate, and then, the plates were incubated at 37 °C for 48 h. Green colonies are interpreted as C. albicans, blue colonies are defined as C. tropicalis, and light white to purple colonies are defined as C. glabrata; purple to pink colonies are defined as C. krusei; and pale colonies are referred to C. parapsilosis.
Microscopic identification
Gram staining
One single colony from each SDA plate was streaked on a clean glass slide, stained with Gram stain and examined microscopically under oil immersion lens.
Germ-tube test
One single colony from each SDA plate was picked up and incubated with 0.5 ml human serum in an Eppendorf at 37 °C for 2–3 h. After incubation, microscopic examination of a loopful from each Eppendorf was carried out (Souza 1998).
Chlamydospores forming test:
The test was performed using rice extract agar medium (REA) (10 g rice, 10 g bacteriological agar, and distilled water adjusted to a final volume of 1000 ml) supplemented with 8 ml of Tween 80 (Montes et al. 2019).
One single colony from SDA plate was streaked (very thinly) on the surface of (REA) plate in 3–4 broad zigzag lines then covered with cover glass and incubated for 9 h at 22–25 °C and then the plate was examined microscopically.
Biotyping
Biochemical identification of the Candida isolates was carried out using API 20C Aux strips. One single colony from young Candida isolate culture taken from SDA plate was immersed into an API 20C suspension tube, and the degree of turbidity was adjusted equal to 2Mcfirland tube. Suspension tube (100 μl) was added to API 20 C medium tube. The cupules of the strip were filled with the suspension from API 20C medium tube, and then, the strips were incubated at 30 °C (for 24, 48 and 72 h). After incubation, the turbidity of cupules was observed and recorded, then a profile number is generated. The obtained figures were subjected to computerized analysis to identify the Candida isolate to species level.
(DNA-based assay; nucleic acid-based assay) genotyping
DNA extraction
DNA extraction of yeast cells was carried out using mini-preparation procedure. To a 1.5-ml Eppendorf tube containing 500 μl of lysis buffer (400 mM Tris–HCl [pH 8.0], 60 mM EDTA [pH 8.0], 150 mM NaCl and 1% sodium dodecyl sulphate), a loopful of yeast colony was added aseptically by using a sterile loop, the tube was then left at room temperature for 10 min. After adding 150 µl of potassium acetate, pH 4.8 (5 M potassium acetate 60 ml, glacial acetic acid 11.5 ml, distilled water 28.5 ml), the tube was vortexed briefly and then centrifuged at > 10,000g for 1 min to remove the cellular debris and precipitated proteins. The supernatant was transferred to another 1.5-ml Eppendorf tube and centrifuged again as above. After transferring the supernatant to a new 1.5-ml Eppendorf tube, an equal volume of isopropyl alcohol was added. The tube was mixed briefly by inversion, centrifuged at > 10,000g for 2 min, and the supernatant was discarded. The resultant DNA pellet was washed in 300 µl ethanol 70% v/v. After centrifuging at 10, 000 g for 1 min, the supernatant was discarded (Lliu et al. 2002). The DNA pellet was added to EZ-10 Spin Columns (Bio Basic Inc.) and centrifuged at > 10,000 g for 10 min. DNA was eluted in 50 µl of 1X TE buffer and stored at − 20 °C.
PCR amplification
The PCR was used to amplify intergenic spacer regions; intertranscribed spacer (ITS) of gene encoding 5.8 S rDNA with primers ITS1 (5'-TCC GTA GGT GAA CCT GCG G-3') and ITS4 (5'-TCC TCC GCT TAT TGA TAT GC-3') (Willowfort.co.UK.). A reaction volume of 50 μl contained 25 μl master mix PCR [0.16 mM each deoxyribonucleoside triphosphate, 5 μl Taq DNA polymerase buffer, 2.5U Taq DNA-dependent DNA polymerase (intron master mix (i-Taq ™)), 0.2 μM each primer and 1 µg genomic DNA as a template. Reaction mixtures were subjected to initial denaturation at 95 °C for 3 min, followed by 35 cycles of denaturation at 95 °C for 1 min, primer annealing at 50 °C for 1 min and elongation for 2 min at 72 °C. Final extension step was performed at 72 °C for 10 min. Negative control was carried out using sterile deionized water instead of template DNA. Red safe stained agarose gel (1.5%) was prepared in 1X TBE buffer (Tris base/boric acid/EDTA). Agarose gel electrophoresis was run at 100 V and the resulting bands were visualized by UV illumination. PCR products were stored at − 20 °C until used (Elena et al. 2015).
Antifungal activity of zinc oxide nanoparticles and commercial antibiotics against Candida isolates
Two commercially available antifungals (nystatin 100 unite/disc—Oxoid) and (Voriconazole 1 µg/disc—Oxoid) and zinc oxide nanoparticles (ZnONPs) used in this study are chemically synthesized and taken from Mona Mohammed Hassan a researcher at national Research Center.
Candida species selected for this test were cultivated on SDA and incubated at 37 °C for 24 h and a yeast suspension in distilled water equal to 1/2 McFarland was done.
A colloidal solution from 10 mg of ZnONPs dissolved in 500 μl distilled water was performed using a sonicator for 5 min. Three different ZnONPs concentrations (25–50–100 µg/disc) were prepared and the yeast suspension was spread on the SDA plate then the discs loaded by ZnONPs were distributed on the plate. The plates were incubated at 37 °C for 48 h. The inhibitory zone (s) was measured after the incubation period and recorded.
Results
Macroscopic and microscopic identification
Out of 118 collected samples inoculated into SDB tubes, 82 revealed turbidity and thus denoted fungal growth. The absence of turbidity in the rest of collected samples showed no fungal elements in these samples. Eighty-two SDA plates separately streaked with loopfuls from 82 SDB turbid tubes showed macroscopically creamy, opaque, smooth and white colonies of different sizes suspected to be Candida spp. (Table 1).
Microscopic examination of Gram stained cultures obtained from 82 samples showed Gram positive (purple), round or ovoid appeared cells with or without budding (Table 1).
Visual examination of culture inoculated CHROMagar plates showed 86 different isolates according to their colours (Fig. 1).
Four more isolates resulted from using CHROMagar plates showed the presence of mixed colonies in some samples.
Out of 86 isolates, 48 showed positive germ tube test which was characterized by microscopic slender tubes erupted from the Candida cells each with straight walls, without septum and constriction at the junction between the cells positive germ tube test is found only with C. albicans and C. dubliniensis (Table 1).
Out of 86 isolates, 47 gave positive Chlamydospores forming test (C. albicans) which was characterized microscopic revealed refractile cell wall with double contours. The rest 48th isolate was non-albicans candida (Table 1).
API 20 C AUX
Upon carrying out API 20C AUX assay on few selected isolates (according to coloured colonies grown on CHROMagar), 9 out of 10 isolates with green coloured colonies revealed Candida albicans (77.8–96.7%) when tested with API 20C. The tenth isolate appeared to be Candida dubliniensis (99%). Nine isolates showing rose colonies on CHROMagar and subjected to API assay revealed the existence of Candida krusei (98.9%). Four isolates showing white colour on CHROMagar and subjected to API assay revealed the existence of Candida glabrata (91.5–99%). One isolate with blue coloured colonies revealed Candida tropicalis (88.9%). Two isolates with pale coloured colonies revealed Candida parapsilosis (99.9%) (Table 2 and Fig. 2).
PCR amplification
PCR assay was applied on 14 selected samples from different coloured colonies. Samples no. 1, 2 and 3 gave a band at 535 pb specific to C. albicans. Sample no 4 gave a band at 524 bp specific to C. tropicalis. Samples no. 5, 6 and 7 gave a band at 510 bp specific to C. krusei. Samples no 8 and 9 gave bands at 520 pb specific to C. parapsilosis samples no. 10,11,12 and 13 gave bands at 871 pb specific to C. glabrata and sample no 14 is negative sample with no band appeared (Fig. 3).
Antifungal activity
The antifungal activity ZnONPs were evaluated against 5 Candida spp. The obtained results showed that discs loaded by low concentrations 25 and 50 ppm not affect the all Candida spp. except C. parapsilosis that inhibited at 50 ppm with 7 mm inhibition zone (Fig. 4), while all Candida spp. were sensitive to 100 ppm of ZnONPs except C. krusei. C. parapsilosis was highly inhibited (42 mm inhibition zone), followed by C. albicans, followed by C. glabrata. Antifungal activities of ZnO NPs and their mode of action were investigated previously (Lili et al. 2011; Arciniegas-Grijalba et al. 2019). ZnONPs remarkably reduced the germ tube formation of C. albicans (Jalal et al. 2018). Recently ZnONPs showed antifungal activity against pathogenic Candida spp. with minimum inhibitory concentration (MIC) and minimum fungicidal concentration (MFC) ranges against Candida spp. was 256–512 µg/ml, respectively (Kermani et al. 2021).
In the (Table 3) the best concentration effect of zinc oxide nanoparticles alone on Candida species was 100 µg/disc.
Discussion
Rapid and accurate identification of Candida species down to the species level is of great importance for the selection of appropriate antifungal agents and for patient management. In the present study, 118 different samples gave 82 Candida isolates on SDB and SDA, while the grown isolates on CHROMagar were 86 isolates. This is due to the presence of mixed Candida infection (the presence of more than one different isolate in the same sample). Five Common Candida Species were found among the present isolates; however, Candida albicans was the most frequently isolated yeast in the present study, its prevalence was lower than a study conducted in Northwest Ethiopia (Mulu et al. 2013) and higher than a study conducted in central Ethiopia (Bitew and Abebaw 2018).
In the Middle East and North Africa, a study demonstrated shift of Candida albicans towards non-albicans Candida species. In the present study, C. krusei was the second predominant species. Our result was similar to that of Bitew and Abebaw (2018), but in contradiction with many other studies where C. glabrata or C. tropicalis was reported as a second predominant non-albicans species (Mulu et al. 2013).
API biochemical assay results were similar to those of CHROMagar except for C. dubliniensis on CHROMagar appeared green colour such as C. albicans but gave positive germ tube and not Chlamydospores former.
Understanding the local epidemiology of Candida is of great relevance for the clinical management of candidiasis. Therefore, it is essential to detect the diversity of Candida, including phenotypic and genotypic features of these pathogens (Cornet et al. 2011). PCR-based approaches can be used to local epidemiological investigation of Candida species (Małek et al. 2017a, b).
To reduce these Candida, commercial antifungals were used, ZnONPs and these ZnONPs were used to reduce the resistance of some types of candida to commercial antifungals, nanoparticles showed an effect on Candida, according to Jalal et al. (2018).
Conclusions
A sheet of identification profile for Candida should include morphotyping, biotyping and genotyping to reach a rapid, reliable and accurate diagnosis. Candida species causes a myriad of infections causing non-invasive, mucocutaneous infections and severe systemic and deep-seated disease. Repress of Candida growth by ZnONPs provides an insight towards their therapeutic application for the prevention of Candida-associated infections. Further studies on the antifungal effect of nanoparticles combined with commercially available antifungal medicines maybe recommended.
Availability of data and materials
All the data included in the current study are available.
Change history
24 November 2021
A Correction to this paper has been published: https://doi.org/10.1186/s42269-021-00662-3
Abbreviations
- SDB:
-
Sabouraud Dextrose Broth
- SDA:
-
Sabouraud Dextrose Agar
- REA:
-
Rice Extract Agar
- PCR:
-
Polymerase Chain Reaction
- DNA:
-
Deoxyribonucleic acid
- EDTA:
-
Ethylene diamine tetra acetic acid
- API:
-
Analytical Profile Index
- NS:
-
Nystatin
- VOR:
-
Voriconazole
- ZnONPs:
-
Zinc Oxide Nanoparticles
References
Ahmad N, Jafri Z, Khan ZH (2020) Evaluation of nanomaterials to prevent oral Candidiasis in PMMA based denture wearing patients. A systematic analysis. J Oral Biol Cranio Fac Res 10(2):189–193. https://doi.org/10.1016/j.jobcr.2020.04.012
Arciniegas-Grijalba PA, Patiño-Portela MC, Mosquera-Sánchez LP, Guerra Sierra BE, Muñoz-Florez JE, Erazo-Castillo LA, Rodríguez-Páez JE (2019) ZnO-based nanofungicides: synthesis, characterization and their effect on the coffee fungi Mycena citricolor and Colletotrichum sp. Mater Sci Eng C Mater Biol Appl 98:808–825. https://doi.org/10.1016/j.msec.2019.01.031
Bitew A, Abebaw Y (2018) Vulvovaginal candidiasis: species distribution of Candida and their antifungal susceptibility pattern. BMC Womens Health 18:94. https://doi.org/10.1186/s12905-018-0607-z
Cornet M, Sendid B, Fradin C, Gaillardin C, Poulain D, Nguyen HV (2011) Molecular identification of closely related Candida species using two ribosomal intergenic spacer fingerprinting methods. J Mol Diagn 13:12–22
Elena R, Simona ES, Diana P, Ionela S, Cojocaru M, Tatiana V (2015) Identification of species of the genus Candida by analysis of 5.8S rRNA gene. Roman Biotechnol Lett 20:4
Hawkins C, Armstrong D (1984) Fungal infections in the immunocompromised host. Clin Haematol 13:599–630
Jalal M, Ansari MA, Ali SG, Khan HM, Rehman S (2018) Anticandidal activity of bioinspired ZnO NPs: effect on growth, cell morphology and key virulence attributes of Candida species. Artif Cells Nanomed Biotechnol Int J 46(1):912–925. https://doi.org/10.1080/21691401.2018.1439837
Kermani SA, Salari S, Almani PG (2021) Comparison of antifungal and cytotoxicity activities of titanium dioxide and zinc oxide nanoparticles with amphotericin B against different Candida species: In vitro evaluation. J Clin Lab Anal 35(1):e23577. https://doi.org/10.1002/jcla.23577
Lili H, Liu Y, Lin AMM (2011) Antifungal activity of zinc oxide nanoparticles against Botrytis cinerea and Penicillium expansum. Microbiol Res 166(3):207–215
Lliu D, Pearce L, Lilley G, Coloe S, Baird R, Pedersen J (2002) PCR identification of dermatophyte fungi Trichophyton rubrum. J Med Microbiol 51(2):117–122
Małek M, Paluchowska P, Bogusz B, Budak A (2017a) Molecular characterization of Candida isolates from intensive care unit patients, Krakow, Poland. Rev Iberoam Micol 34(1):10–16. https://doi.org/10.1016/j.riam.2016.03.005
Małek M, Paluchowsk P, Bogusz B, Budak A (2017b) Molecular characterization of Candida isolates from intensive care unit patients, Krakow, Poland. Rev Iberoam Micol 34:1. https://doi.org/10.1016/j.riam.2016.03.005
Marinho SA, Teixeira AB, Santos OS, Cazanova RF, Ferreira CA, Cherubini K, de Oliveira SD (2010) Identification of Candida spp. by phenotypic tests and PCR. Braz J Microbiol 41(2):286–294. https://doi.org/10.1590/S1517-83822010000200004
Montes K, Ortiz B, Galindo C, Figueroa I, Braham S, Fontecha G (2019) Identification of Candida species from clinical samples in a Honduran Tertiary Hospital. Pathogens 8(4):237. https://doi.org/10.3390/pathogens8040237
Mulu A, Kassu A, Anagaw B, Moges B, Gelaw A, Alemayehu M et al (2013) Frequent detection of ‘azole’ resistant Candida species among late presenting AIDS patients in northwest Ethiopia. BMC Infect Dis 13:82
Ogaba OM, Abia-Bassy LN, Epoke J, Mandor BI, Iwatt GD (2013) Characterization of Candida species isolated from cases of lower respiratory tract infection among HIV/AIDS patients in Calabar, Nigeria. World J AIDS 3:201–206
Page BT, Kurtzman CP (2005) Rapid identification of Candida species and other clinically important yeast species by flow cytometry. J Clin Microbiol 43(9):4507–4514
Souza VM (1998) Técnicas laboratoriais utilizadas em micologia médica. In: Zaitz C, Campbell I, Marques AS, Ruiz LR, Souza VM (eds) Compêndio de micologia médica. Medsi, Rio de Janeiro, pp 51–63
Zhang J, Hung GC, Nagamine K, Li B, Tsai S, Lo SC (2016) Development of Candida-specific real-time PCR assays for the detection and identification of eight medically important Candida species. Microb Insights 9(21):28
Acknowledgements
We thank Prof. Dr. Muhammad Rushdy, professor at the Faculty of Science, Al-Azhar University, for contributing to the design of the research protocol and we thank Dr. Mona Mohamed Hassan, a researcher in the Microbiology and Immunology department at the National Research Center, for providing some materials to complete the research.
Funding
No found was available.
Author information
Authors and Affiliations
Contributions
TM, MM and AS conceived and designed the study. AS and MM carried out most of the laboratory work. AS, TM and MM analysed and interpreted the data. AS, MM and TM helped in writing—original draft. All authors read and approved the final manuscript.
Corresponding author
Ethics declarations
Ethics approval and consent to participate
The study protocol was approved by the Ethics Committee of the National Research Center, Cairo, Egypt under number (72117082021).
Consent for publication
Not applicable.
Competing interests
The authors have no conflict of interest to declare.
Additional information
Publisher's Note
Springer Nature remains neutral with regard to jurisdictional claims in published maps and institutional affiliations.
The authors notified an error in the affiliation list
The wrong list currently read:
Anas Salama Sayed Hemaid1*, Mohamed Mahmoud Efat Abdelghany2 and Tarek Mohamed Abdelghany2
The correct list should read:
Anas Salama Sayed Hemaid1*, Mohamed Mahmoud Efat Abdelghany2 and Tarek Mohamed Abdelghany1
Rights and permissions
Open Access This article is licensed under a Creative Commons Attribution 4.0 International License, which permits use, sharing, adaptation, distribution and reproduction in any medium or format, as long as you give appropriate credit to the original author(s) and the source, provide a link to the Creative Commons licence, and indicate if changes were made. The images or other third party material in this article are included in the article's Creative Commons licence, unless indicated otherwise in a credit line to the material. If material is not included in the article's Creative Commons licence and your intended use is not permitted by statutory regulation or exceeds the permitted use, you will need to obtain permission directly from the copyright holder. To view a copy of this licence, visit http://creativecommons.org/licenses/by/4.0/.
About this article
Cite this article
Hemaid, A.S.S., Abdelghany, M.M.E. & Abdelghany, T.M. Isolation and identification of Candida spp. from immunocompromised patients. Bull Natl Res Cent 45, 163 (2021). https://doi.org/10.1186/s42269-021-00620-z
Received:
Accepted:
Published:
DOI: https://doi.org/10.1186/s42269-021-00620-z